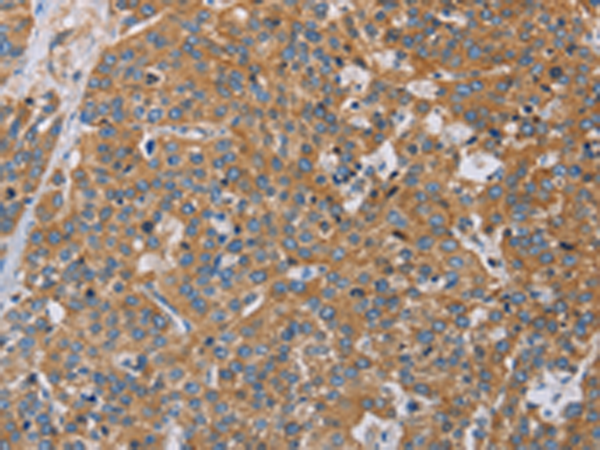

中文名稱: 兔抗ACTN4多克隆抗體
|
Background: |
Alpha actinins belong to the spectrin gene superfamily which represents a diverse group of cytoskeletal proteins, including the alpha and beta spectrins and dystrophins. Alpha actinin is an actin-binding protein with multiple roles in different cell types. In nonmuscle cells, the cytoskeletal isoform is found along microfilament bundles and adherens-type junctions, where it is involved in binding actin to the membrane. In contrast, skeletal, cardiac, and smooth muscle isoforms are localized to the Z-disc and analogous dense bodies, where they help anchor the myofibrillar actin filaments. This gene encodes a nonmuscle, alpha actinin isoform which is concentrated in the cytoplasm, and thought to be involved in metastatic processes. |
|
Applications: |
ELISA, WB, IHC |
|
Name of antibody: |
ACTN4 |
|
Immunogen: |
Fusion protein of human ACTN4 |
|
Full name: |
actinin, alpha 4 |
|
Synonyms: |
FSGS; FSGS1; ACTININ-4 |
|
SwissProt: |
O43707 |
|
ELISA Recommended dilution: |
2000-5000 |
|
IHC positive control: |
Human esophagus cancer and Human thyroid cancer |
|
IHC Recommend dilution: |
50-200 |
|
WB Predicted band size: |
105 kDa |
|
WB Positive control: |
Lovo cells and mouse kidney tissue, 231 and hepG2 cells |
|
WB Recommended dilution: |
500-2000 |

購物車
購物車 幫助
幫助
 021-54845833/15800441009
021-54845833/15800441009
